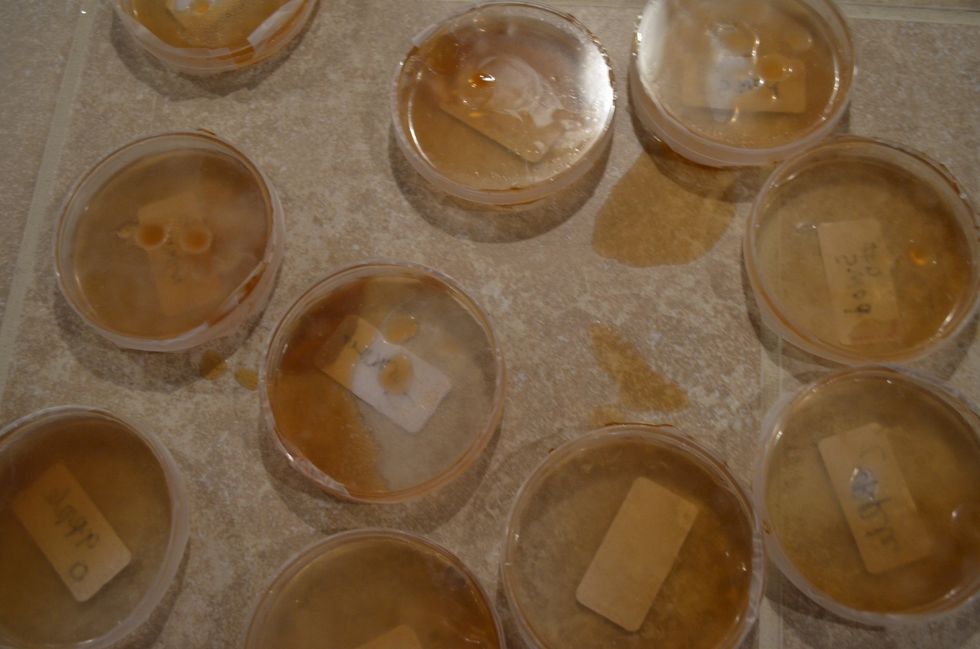
Ewwww. I stored the dishes lid-side down and they leaked. The light bulb didn't keep the dishes at 90 degrees. I saw cloudiness and specks in all dishes, but could not tell which had more germs.

STEPS
TOOLS

Note: Jillian Clarke was a freshman in college when she won the Ig Nobel Award for testing the 5-second rule. She concluded it is NOT safe to eat food that is on the ground less than 5 seconds.

Choose the food you want to test. I chose crackers and apple pieces to see if there is a difference between dry, bumpy surfaces and moist, smooth surfaces.

It's fun to dump stuff in water. Plain gelatin and sugar go in.

The beef bouillon stinks.

Bring mixture to boil. Let cool for 8 to 10 minutes.

Pour mixture into Petri dishes, 1/3 to 1/2 full. You have enough mixture for 20 to 30 dishes. Feed leftover to your little brother.

Put dishes into refrigerator for a couple of hours to set the gel.

After agar gel hardens, let's get stickin'. Make labels that say what you plan to smear on the agar gel.

This is "swab, 0 seconds" in dyslexic.

Let's see if there are germs on the cotton swabs. Swab one gel with a swab right out of the pack. Then drop a swab for 2 seconds, another for 5 seconds, and another for 10 seconds.

Rub each swab directly on its own gel, then cover with the lid with the right label.

Cracker time. Drop three crackers on the floor for 2, 5, and 10 seconds.

Swab each cracker and then smear it on its own, properly labeled Petri dish.

Same thing with apple pieces.

Tape the lids onto the Petri dishes. Be sure to store the dishes lid-side up.

Keep the dishes at 90 degrees F for up to 72 hours. Make observations every 24 hours. More specks on some dishes than others?
Ewwww. I stored the dishes lid-side down and they leaked. The light bulb didn't keep the dishes at 90 degrees. I saw cloudiness and specks in all dishes, but could not tell which had more germs.
- 4 packets plain gelatin
- 8 tsp sugar
- 4 tsp beef bouillon granules, cubes or concentrate
- Petri dishes
- Cotton swabs
- 4 pieces of two kinds of food
- Stopwatch
- Thermometer
- Heat source
The Conversation (0)
Sign Up